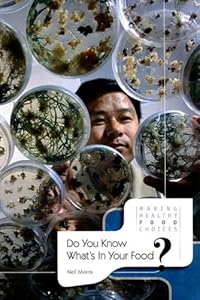
Do You Know What's In Your Food? (Making Healthy Food Choices)
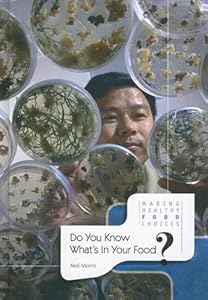
Do You Know What's In Your Food? (Making Healthy Food Choices)

Neil Morris
Neil Morris worked in publishing for more than ten years before becoming a writer of children's books. After studying German at Swansea University, he began his career as a lexicographer, helping to compile a German-English dictionary. He is the author of titles such as My First Encyclopedia, Hurricanes & Tornadoes, and Prehistory.
Children's Non-fiction
Educational

Living in the Mountains (Where People Live)

Living by Lakes (Where People Live)

Volcanoes (Wonders of Our World)

Wonders of the World Atlas

Earthquakes (Natural Disasters)

Solar Power (Energy Sources)

Do You Know Where Your Food Comes From? (Making Healthy Food Choices)

Saving Water

Geothermal Power (Energy Sources)

Voyages of Discovery (History of the World)
Do You Know What's In Your Food? (Making Healthy Food Choices)

The Industrial Revolution (Research It!)
Do You Know What's In Your Food? (Making Healthy Food Choices)

Hurricanes & Tornadoes (Natural Disasters)

Biomass Power (Energy Sources)

Water Power (Energy Sources)

Global Warming (What If We Do Nothing?)

What Does Space Exploration Do for Us?

The Student's Activity Atlas

Native American Myths (Myths from Many Lands)

Food for Sports (Making Healthy Food Choices)

Wind Power

Transportation

Lost Cities (Amazing History)